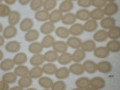

|
||
|
 About "SilkwormBase"
About "SilkwormBase"
|
|
| Strains | |
 Classification by phenotype
Classification by phenotype
|
|
 Strain list
Strain list 
|
|
 Images
Images 
|
|
 Larva period time list
Larva period time list
|
|
 Feeding ability of artificial diets (list)
Feeding ability of artificial diets (list)
|
|
 |
 Field search
Field search 
|
| Bombyx mandarina | |
 |

|
 DNA Locality Map
DNA Locality Map 
|
|
| BmN cell line | |
 Cell lines and Fee
Cell lines and Fee
|
|
| Genes | |
 Classification
Classification
|
|
 Features
Features
|
|
 All genes
All genes
|
|
 Field search
Field search 
|
|
 Linkage maps
Linkage maps
|
|
| References | |
 Reference list
Reference list 
|
|
 Reference Feedback
Reference Feedback
|
|
| Distribution request | |
 How to request
How to request
|
|
 How to Place a Web Order
How to Place a Web Order
|
|
 Pricing of Silkworm
Pricing of Silkworm

(Oct. 2019 updated) |
|
 MTA
MTA 
(Mar.22,2024 Updated) |
|
 Rearing Schedule
Rearing Schedule
|
|
| Related sites | |
 Links
Links
|
|
ver 3.6.17
Copyright © 2014 NBRP-Silkworms. All rights reserved.
Copyright © 2014 NBRP-Silkworms. All rights reserved.

_egg.gif)
_egg.jpg)
_egg.gif)
_egg.jpg)
_egg.gif)
_egg.jpg)



















